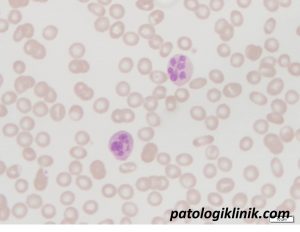
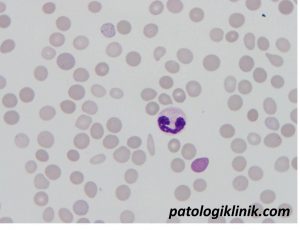

Anemia Megaloblastik

Anemia megaloblastik adalah kumpulan penyakit yang disebabkan oleh gangguan sintesis DNA, disebabkan oleh defisiensi kobalamin (Vit B12) dan/atau asam folat.. Sel terutama yang terkena adalah sel yang pertukarannya (turn over) cepat, terutama sel prekursor hematopoetik dan sel epitel gastro-intestinal.
Gangguan Absobsi atau metabolism folat atau Vit. B12 menyebabkan sintesis DNA akan dihambat dan siklus sel jadi diperlambat selama eritropoesis. Namun sintesis hemoglobin di sitoplasma berlangsung terus dan tidak mengalami perubahan sehingga ukuran eritrosit muda membesar dan eritrosit yang oval akan masuk kedalam darah. Pembentukan granulosit dan megakariosit juga terganggu. Di samping gangguan proliferasi, anemia juga dicetuskan oleh kerusakan dini eritrosit muda di sumsum tulang (peningkatan eritropoesis yang tidak efisien) dan juga karena pemendekan masa hidup eritrosit di sirkulasi.
Penyebab kekurangan asam folat:
- Asupan Folat yang sedikit dari makanan (< 50µg/hari, pemasakan yang lama merusak folat)
- Kebutuhan yang meningkat (kehamilan)
- Malabsorbsi, misalnya penyakit usus halus atau penghambatan pembawa folat oleh metatotreksat.
- penghambatan pembawa folat oleh obat-obatan seperti metatokresat
- Defisiensi kobalamin
Penyebab kekurangan B12:
- Asupan yang sangat kurang (diet vegetarian yang ketat)
- Defisiensi faktor intrinsk (IF) (pada gastritis atrofi) diperlukan untuk pengikatan dan absorbsi kobalamin.
- Pemecahan IF oleh bakteri (blind-loop Syndrome) atau cacing pita di usus.
- Kelainan (congenital, setelah reseksi) atau peradangan ileum terminalis, yaitu tempat penyerapan kobalamin.
- Kelainan Transkobalamin II (TC II), yang berperan untuk transport kobalamin di plasma dan pengambilannya dalam sel.
Gejala Klinis
- Gejala gangguan pencernaan: kehilangan nafsu makan, penurunan berat badan, mual, sembelit, sariawan dan sakit pada lidah
- Tanda-tanda anemia
- Gangguan Neurologis : parastesi tangan dan kaki, kehilangan memori selanjutnya jika keadaan memberat dapat mempengaruhi gaya berjalan, kebutaan akibat atropi N.Optikus dan gangguan kejiwaan
Pemeriksaan Laboratorium:
Pada pemeriksaan darah lengkap bisa ditemukan anemia dengan MCV yang meningkat >100 fL (makrositosis), kadang disertai dengan leukopenia dan/atau trombositopenia. Pada apusan darah tepi terlihat gambaran anisopoikilositosis disertai makroovalosit dan hipersegmentasi netrofil. Kadang juga ditemui eritrosit muda (normoblas).

Sumsum tulang tampak hiperseluler dengan penurunan rasio myeloid/ertitroid dan peningkatan cadangan besi. Anemia megaloblastik ditandai oleh produksi eritrosit yang tidak efektif.

Pemeriksaan kadar asam folat dan vit. B12 darah sangat membantu dalam menentukan adanya defisiensi asam folat dan vit B12, tetapi sayangnya pemeriksaan ini hanya tersedia di kota-kota besar dan harganya cukup mahal. Berikut nilai rujukan dari asam folat dan vit. B12
asam folat 165–760 ng/mL
vit. B12 140–820 pg/mL
Semoga bermanfaat.
Referensi:
Carmel R. Wintrobe’s Clinical Hematology 12th ed in Megaloblastic Anemias: Disorder of Impaired DNA Synthesis. 2008;(1):1143-65.




![[Download] Pedoman Nasional Pelayanan Kedokteran Tata Laksana Thalassemia (KMK)](/content/images/uploads/2022/10/KMK.jpg)
![[Download] Pemeriksaan Laboratorium pada Thalassemia](/content/images/uploads/2022/09/cover-web-scaled.jpg)